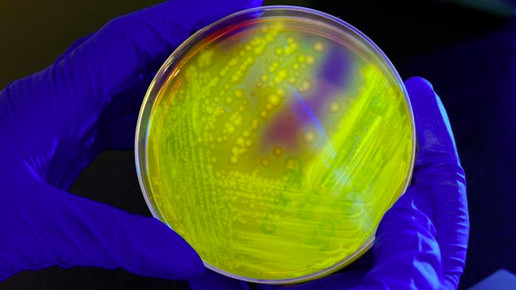
bakterien CDC melissa dankel

Hoffnungsträger und Innovationen 2018
Auch 2018 sollen neue Medikamente die Versorgung der Patienten verbessern. Der Verband forschender Arzneimittelhersteller (vfa) rechnet auch im kommenden Jahr mit mindestens 30 Neueinführungen – etwa ein Drittel soll der Behandlung von Krebspatienten dienen. Auch neue resistenzbrechende Antibiotika sind unter den potentiellen Kandidaten.
Der vfa erwartet für das neue Jahr neben Neueinführungen zur Behandlung von bestimmten Formen von Leukämie, Lymphknotenkrebs oder Hautkrebs sowie Brust- und Eierstockkrebs auch Innovationen zur Regulation der Blutgerinnung und zur Behandlung von seltenen Erkrankungen wie der Erbkrankheit Morbus Wilson oder der Mukopolysaccharidose VII. Völlig neu könnten 2018 auch maßgeschneiderte Krebstherapie wie die CAR-T-Zelltherapie sein. Patientenindividuell werden Immunzellen der Betroffenen im Labor gentechnisch so „ausgerüstet“, das sie zurück im Körper die Tumorzellen erkennen und attackieren.
Kurz vor der EU-Zulassung steht beispielsweise Ocrevus (Ocrelizumab, Roche). Das Arzneimittel könnte das erste Medikament gegen die primär progressive Multiple Sklerose (PPMS) sein. Ocrelizumab ist ein humanisierter monoklonaler Antikörper, der sich von dem bekannten Krebs- und Rheumamittel Rituximab ableitet. Der Wirkstoff richtet sich selektiv gegen CD20-positive B-Lymphozyten. Diese speziellen Immunzellen sind vermutlich für die Schädigung der die Nervenfasern schützenden Myelinscheiden und der Axone verantwortlich. In der Folge können Behinderungen entstehen.
Ocrevus könnte diese Neurodegenerationen ausbremsen. Der Arzneistoff bindet spezifisch an CD20-positive B-Zellen und interagiert nicht mit Zellen des Immunsystems. Neue B-Zellen werden weiterhin gebildet und das Gedächtnis des Immunsystems wird nicht beeinträchtigt. Entzündungen werden unterdrückt, Schübe vermindert und die fortschreitende Behinderung verlangsamt. Das Medikament könnte nach Zulassung alle sechs Monate zu 600 mg als Infusion verabreicht werden.
Prevymis (Letermovir, AiCuris) hatte im November eine Zulassungsempfehlung erhalten. Das Arzneimittel besitzt in der EU den Status Orphan Drug und könnte zur Prävention von Cytomegalievirusinfektionen eingesetzt werden. Der Wirkstoff ist gegen die virale DNA-Synthese gerichtet und hemmt Formierung und Freisetzung von Viruspartikeln. Letermovir ist ein oraler, nicht-nukleosider Inhibitor der CMV-Terminase.
Benralizumab ist in den USA bereits zugelassen – für dier EU steht diese für das Asthmamedikament noch aus und wird für das erste Quartal 2018 erwartet. Das Arzneimittel von AstraZeneca könnte unter dem Namen Fasenra auf den Markt kommen. Der monoklonale humanisierte IgG1-Antikörper besitzt einen dualen Wirkmechanismus. Der Arzneistoff bindet zum einen an die Alpha-Untereinheit des Interleukin-5-Rezeptors auf eosinophilen Granulozyten und hemmt so die Bindung von IL-5 an den Rezeptor. In der Folge wird die Aktivierung eosinophiler Granulozyten verhindert. Zum anderen aktiviert Benralizumab durch Bindung mit dem Fc-Fragment natürliche Killerzellen. Es folgt eine Apoptose der eosinophilen Granulozyten über eine Antikörper-abhängige zellvermittelte Zytotoxizität.
Die Zulassungsempfehlung für Benralizumab umfasst die Add-on-Erhaltungstherapie für erwachsene Patienten mit schwerem eosinophilen Asthma, die trotz hochdosierter inhalativer Kortikosteroide und einem lang wirksamen Beta-Antagonisten unzureichend kontrolliert ist.
Shingrix (GSK) könnte als rekombinanter Totimpfstoff dem bislang einzigen zugelassenen Gürtelrose-Impfstoff Zostavax (MSD) Konkurrenz machen. Das Beratungskomitee für Impfstoffe der US-Arzneimittelagentur (FDA) hatte im September einstimmig die Zulassung für die Herpes-zoster-Vakzine empfohlen. Die EU-Zulassung wurde im November vergangenen Jahres beantragt.
Für Rexulti (Brexpiprazol, Otsuka) wurde im März der EU-Zulassungsantrag eingereicht. Das Medikament könnte gegen Schizophrenie auf den Markt kommen und befindet sich in der Entwicklung gegen Depression und Alzheimer. Brexiprazol ist ein Dopamin D2 und D3- Rezeptorantagonist und mit Aripiprazol eng verwandt. In den USA wurde das Arzneimittel bereits 2015 zugelassen.
Hemlibra (Emicizumab, Roche/Chugai) soll als neues Medikament gegen Hämophilie A auf den Markt kommen. Der asymmetrische bispezifische Antikörper, bindet sowohl an Faktor X als auch an Faktor IX und verhält sich wie der natürliche Faktor VIII. Das Arzneimittel ist auch wirksam, wenn die Patienten gegen Faktor VIII Antikörper gebildet haben.
The Medicines Company hat für die Wirkstoffkombination Meropenem, ein bekanntes Antibiotikum und Vaborbactam einen Zulassungsantrag gestellt. Das Arzneimittel richtet sich gegen gramnegative Bakterien und könnte gegen komplizierte Harnwegsinfekte eingesetzt werden. Vaborbactam ist selbst kein Antibiotikum, erhält jedoch durch Hemmung der Betalactamase die Wirksamkeit von Meropenem.
Mit Eravacyclin wurde ein weitere Zulassungsantrag für ein neues Antibiotikum gestellt. Das Breitbandantibiotikum aus der Gruppe der Fluorocycline könnte gegen komplizierte Bauchrauminfektionen, auch wenn die Erreger gegen Tetracyclin resistent sind.
In den USA ist Kymriah (Tisagenlecleucel, Novartis) als CAR-T-Zell-Therapie gegen akute lymphatische Leukämie und diffuse großzellige B-Zell-Lymphome bereits zugelassen. Im November wurde der EU-Zulassungsantrag eingereicht. Das Arzneimittel besitzt in der EU den Status Orphan Drug. Es handelt sich um eine individuelle Therapie, deren Wirkstoff aus den T-Zellen der Patienten besteht. Diese werden durch einen gentechnischen Eingriff so verändert, dass sie einen chimären Antigen-Rezeptor exprimieren. Dieser ermöglicht eine Bindung an CD-19-tragende Zellen und in der Folge deren Zerstörung.
Im November wurde in den USA Yescarta (Axicabtagen Ciloleucel, Kite) zugelassen. Hierbei handelt es sich ebenfalls um eine CAR-T-Therapie. Der Listenpreis lag bei 373.000 US-Dollar. Die Therapie kann mit schwerwiegenden Nebenwirkungen einhergehen. Die Fachinformation enthält daher ein „boxed warning“ für das Zytokin-Freisetzungssyndrom (CRS) und neurologische Toxizitäten. Die EMA prüft die Zulassung bereits, ein Ergebnis wird für das erste Halbjahr 2018 erwartet.

APOTHEKE ADHOC Debatte